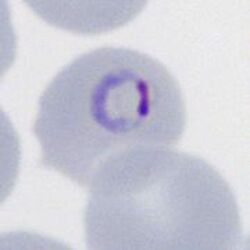

Double chromatin dot forms
From haematologyetc.co.uk
Navigation
Go Back
| What is a double dot form?
Early or late trophozoites where the chromatin dot has two separate masses - a double dot that is sometimes said to resemble a signet ring, although this really only applies for typical ring forms where dots are relatively close together.
Note how the chromatin dot of the ring form is divided into two purple masses
Species significance Most often this appearance seen in infection with P.falciparum and can be helpful to indicate this species; however the form is not fully specific and may occur in any species. Additional images Malaria double chromatin dot forms in: late trophozoite of P.ovale (A) an early trophozoite of P.vivax (B) and ealy trophozoite of P.knowlesi (C) |